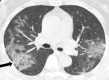

Coronavirus Disease 2019: Initial Detection on Chest CT in a Retrospective Multicenter Study of 103 Chinese Patients
- PMID: 33778564
- PMCID: PMC7194021
- DOI: 10.1148/ryct.2020200092
Coronavirus Disease 2019: Initial Detection on Chest CT in a Retrospective Multicenter Study of 103 Chinese Patients
Abstract
Purpose: To evaluate the performance of chest CT regarding the initial presentation of patients suspected of having coronavirus disease 2019 (COVID-19).
Materials and methods: Data from 103 patients who were under investigation for COVID-19 based on inclusion criteria according to the World Health Organization Interim Guidance were retrospectively collected from January 21, 2020, to February 14, 2020. All patients underwent chest CT scanning and reverse-transcription polymerase chain reaction (RT-PCR) testing for COVID-19 at hospital presentation. The sensitivity, specificity, positive predictive value (PPV), and negative predictive value (NPV) (with 95% confidence intervals) were calculated to evaluate the performance of CT. Subgroup analyses were also performed based on the geographical distribution of these cases in the province of Henan, China.
Results: There were 88/103 (85%) patients with COVID-19 confirmed by RT-PCR testing. The overall sensitivity, specificity, PPV, and NPV were 93% (85%, 97%), 53% (27%, 77%), 92% (83%, 96%), and 42% (18%, 70%), respectively. Similar results were shown in both geographic regions. The respective sensitivity, specificity, PPV, and NPV for chest CT in the districts of Xinyang and Zhumadian (n = 56) were 92% (80%, 97%), 63% (26%, 90%), 93% (81%, 98%), and 56% (23%, 85%), while these indicators in the district of Anyang (n = 47) were 95% (81%, 99%), 43% (12%, 80%), 90% (76%, 97%), and 60% (17%-93%). There were no significant differences in the prevalence of positive examinations in the two geographic subgroups for CT (P = .423) or RT-PCR (P = .931).
Conclusion: Although initial chest CT obtained at hospital presentation showed high sensitivity in patients under investigation for COVID-19 in the two geographic regions in Henan Province, the NPV was only modest, suggesting a low value of CT as a screening tool.© RSNA, 2020.
2020 by the Radiological Society of North America, Inc.
Conflict of interest statement
Disclosures of Conflicts of Interest: Z.W. disclosed no relevant relationships. Y.C. disclosed no relevant relationships. L.Z. disclosed no relevant relationships. H.L. disclosed no relevant relationships. K.D. disclosed no relevant relationships. Z.L. disclosed no relevant relationships. J.C. disclosed no relevant relationships. L.C. disclosed no relevant relationships. D.W. disclosed no relevant relationships.
Figures

References
-
- World Health Organization . Clinical management of severe acute respiratory infection when novel coronavirus (nCoV) infection is suspected: interim guidance. World Health Organization Web site. https://apps.who.int/iris/handle/10665/331446. Published January 12, 2020.
-
- World Health Organization . Novel coronavirus: Thailand (ex-China). World Health Organization Web site. https://www.who.int/thailand/emergencies/novel-coronavirus-2019. Published January 14, 2020. Accessed January 19, 2020.
LinkOut - more resources
Full Text Sources

